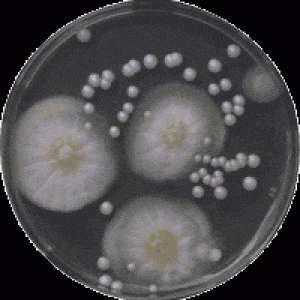

Barotnes un barotņu piedevas mikrobioloģijai.
Medicīniskās diagnostikas reaģenti.
Veterinārmedicīnas diagnostikas reaģenti un komplekti.
Barotnes un barotņu piedevas mikrobioloģijai
- Dehidratētās (sausās) barotnes, iepakojumā 500 g;
- Barotņu piedevas;
- Lietošanai gatavās barotnes.
Bakterioloģiskie testēšanas reaģenti, serumi un antigēni
- Salmonella diagnostika (poliklonālie un monoklonālie);
- Shigella diagnostika;
- Yersinia diagnostika;
- Coli diagnostika;
- Rabies diagnostika.
Asinsgrupu noteikšanas reaģenti un kartes
- Serafol® AB0 kartes;
- Serafol® AB0+D kartes;
- Asinsgrupu noteikšanas reaģenti;
- Monoklonālās antivielas
- Mājdzīvnieku un zivju infekcijas slimību diagnostikas ELISA testi;
- Dzīvnieku antivielu konjugāti (arī ar fluorescentajiem marķeriem);
- Imunoenzimātiskie un imunofluorescentie testi;
- Diagnostiskās teststrēmeles.
Pirkšanas iespējas
Projekts Latvijā Radīts realizēts sadarbībā ar AS "Attīstības finanšu institūciju Altum”,
Eiropas Sociālā fonda projekta NR 9.1.1.3/15/I/001 "Atbalsts sociālajai uzņēmējdarbībai" un Labklājības ministrijas atbalstu.
SIA LAIMA LV
ir sociālā uzņēmuma statuss un tas ir Latvijas Sociālās
uzņēmējdarbības asociācijas biedrs.
Projekts Latvijā Radīts
atbalsta sociālo uzņēmējdarbību un cilvēkus ar īpašām vajadzībām, nodrošinot bezmaksas iespējas informācijas un reklāmas izvietošanai projekta ietvaros.
www.latvijaradits.lv interneta platformā pirkšanas/pārdošanas darījumi tiek veikti starp pircēju un pārdevēju, abām pusēm savstarpēji vienojoties par visiem ar pirkuma piegādi un apmaksu saistītajiem jautājumiem.
www.latvijaradits.lv interneta platforma nepilda finanšu operāciju starpnieka lomu un tā neuzņemas nekādu atbildību par pārdošanas / pirkšanas darījumiem.
Sadarbības interesēs ar mums var sazināties pa tālruni: +371 29438344 vai rakstot uz elektroniskā pasta adresi:
Sadarbības partneriem
Latvijaradits.lv datu bāzē iekļautās informācijas, vai informācijas daļas pavairošana vai izplatīšana ir stingri aizliegta. Sadarbības interesēs ar mums var sazināties pa tālruni: +371 29438344 vai rakstot uz elektroniskā pasta adresi:
© Latvijā Radīts. Visas tiesības paturētas.